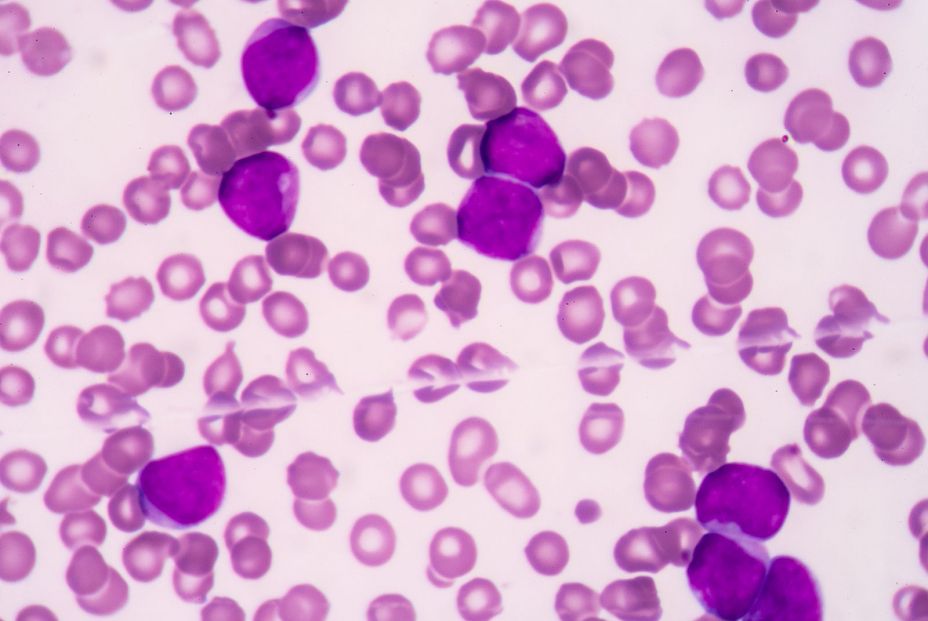
bigstock Acute Myeloblastic Leukemia am 96205286

Un nuevo análisis de sangre podría detectar el riesgo de leucemia
Esta prueba podría reemplazar el procedimiento diagnóstico invasivo de la toma de médula ósea
Nuevo hallazgo: fármacos para el colesterol elevan la supervivencia en dos tipos de cáncer de sangre
La base para comprender y definir los estados fisiopatológicos humanos reside en una descripción detallada de la heterogeneidad interindividual en individuos sanos. Estudios poblacionales a gran escala han identificado amplias diferencias interindividuales en los hemogramas completos (HC), un análisis de sangre que evalúa varios componentes y características de la sangre, incluyendo glóbulos rojos, glóbulos blancos y plaquetas, de individuos y han revelado diferentes cambios en los hemogramas relacionados con la edad, como un alto ancho de distribución de eritrocitos (RDW), anemia macrocítica y una reducción en el recuento absoluto de linfocitos. El establecimiento de valores de referencia, o rangos normales a nivel poblacional para ciertos parámetros sanguíneos, ha sido crucial para la evaluación, el diagnóstico y el tratamiento de los pacientes.
Si bien los rangos de referencia del hemograma completo se utilizan a diario en la clínica, aún no se ha establecido uno equivalente para las células madre y progenitoras hematopoyéticas (HSPC), como recuerda un estudio de 'Journal of Internal Medicine'.
Dado que las HSPC residen principalmente en la médula ósea (MO), el acceso a estas células, especialmente en la población sana, ha sido problemático, mientras que su escasez general en la circulación dificultaba considerablemente su caracterización eficiente a partir de la sangre. Esto se ha hecho posible gracias a tecnologías modernas como la secuenciación de ARN de células individuales (scRNA-seq).
La heterogeneidad individual en la frecuencia de las HSPC circulantes (cHSPC) se ha reportado en el pasado y se relacionó con la edad, el sexo, el tabaquismo, los perfiles lipídicos y los factores hereditarios, se recoge en un estudio de 'Blood', así como con diferentes estados patológicos, documenta otro ensayo. Pocos estudios han analizado la heterogeneidad de las HSPC con mayor resolución, pero su tamaño de participantes. Trabajos previos,incluyendo algunos basados en el análisis de scRNA-seq , demostraron que la mayoría de las subpoblaciones de HSPC se pueden identificar en la sangre periférica (SP) y se identificaron células madre funcionales en la SP de ratones y humanos .
Nuevas evidencias
¿Qué pasaría si un análisis de sangre pudiera revelar el ritmo de nuestro envejecimiento y las enfermedades que nos aguardan? Los laboratorios de los profesores Liran Shlush y Amos Tanay, del Instituto de Ciencias Weizmann, han realizado estudios exhaustivos sobre la biología de la sangre para comprender mejor el proceso de envejecimiento y por qué algunas personas se vuelven más susceptibles a las enfermedades con el paso de los años. Sus equipos de investigación, compuestos por médicos, biólogos y científicos de datos, han estado rastreando los cambios en las células madre hematopoyéticas, incluyendo la aparición de cambios genéticos en estas células en aproximadamente un tercio de las personas mayores de 40 años. Estos cambios no solo aumentan el riesgo de cánceres de la sangre como la leucemia, sino que también se han relacionado con enfermedades cardíacas, diabetes y otras afecciones relacionadas con la edad.
En un nuevo estudio, publicado en Nature Medicine, apenas días después de que sus laboratorios sufrieran graves daños en un ataque con misiles iraníes, Shlush y Tanay presentan hallazgos que podrían conducir al desarrollo de un innovador análisis de sangre para detectar el riesgo de desarrollar leucemia. Esta prueba podría reemplazar el procedimiento diagnóstico invasivo de la toma de médula ósea.
El estudio se centró en el síndrome mielodisplásico (SMD), una afección relacionada con la edad en la que las células madre sanguíneas no maduran adecuadamente para convertirse en células sanguíneas funcionales. Diagnosticar el SMD y evaluar su gravedad es crucial, ya que puede provocar anemia grave y progresar a leucemia mieloide aguda, uno de los cánceres de sangre más comunes en adultos. Hasta ahora, el diagnóstico se basaba en la toma de una muestra de médula ósea, un procedimiento que requiere anestesia local y puede causar molestias o dolor.
En el nuevo estudio, un equipo de investigación dirigido por la Dra. Nili Furer, Nimrod Rappoport y Oren Milman, en colaboración con médicos e investigadores de Israel y EE. UU ha demostrado que las células madre sanguíneas raras —que ocasionalmente salen de la médula ósea y entran en el torrente sanguíneo— contienen información diagnóstica sobre el SMD. Los investigadores demostraron que con un simple análisis de sangre y una secuenciación genética unicelular avanzada, es posible identificar los primeros signos del síndrome e incluso evaluar el riesgo de una persona de desarrollar cáncer de sangre.
En marcha un ensayo clínico a gran escala
También descubrieron que las células madre migratorias pueden servir como un reloj para nuestra edad cronológica, y que en los hombres, su población cambia antes que en las mujeres, lo que aumenta el riesgo de cáncer. Este hallazgo podría explicar la mayor prevalencia de cánceres de la sangre en hombres. Los científicos creen que el uso de la prueba para diagnosticar SMD y leucemia es solo el comienzo, y que en el futuro podría aplicarse a una variedad de otros trastornos hematológicos. Los hallazgos actuales ya se están probando en un ensayo clínico a gran escala en varios centros médicos de todo el mundo.
Además de su investigación de laboratorio, Shlush es médico sénior en el Centro Médico Assuta de Ashdod (Isarael y en Maccabi Healthcare Services,y dirige la recién creada Escuela de Medicina Miriam y Aaron Gutwirth del Instituto Weizmann. Esta escuela se fundó para abordar las nuevas necesidades y desafíos del mundo de la medicina y la investigación, y para reducir, en la medida de lo posible, la brecha entre la ciencia actual y la medicina del futuro. A diferencia de los programas existentes en todo el mundo que combinan la medicina con la investigación, se espera que el nuevo programa unifique e integre los componentes clínicos y de investigación. La escuela abrirá sus puertas por primera vez el próximo octubre y su objetivo es formar a la próxima generación de médicos-científicos.
